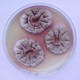
Aem micologia mycoloy colonias bolgut124 02 cya20s 7d fj cabañes aemicol.com .jpg
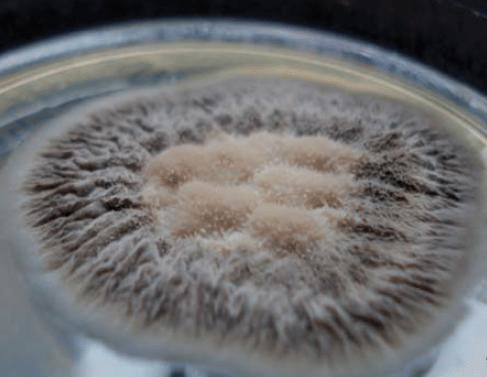
Dermatología: Benjamin Schenck
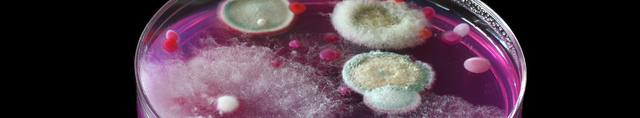
Biotecnología: C.T. Bishop y F. Blank

-
Atribuyeron a las setas múltiples propiedades, las consideraban un "alimento de los dioses" que aportaba la inmortalidad a quienes las consumían.
-
Veneraban a los hongos de piedra por su divinidad y espiritualidad
-
Fue el primero en documentar la candidiasis pseudomembranosa con el nombre de “afta alba"
-
Citaba el envenenamiento de una familia por consumo de hongos venenosos
-
Se encuentran esculturas mesoamericanas para rendir tributo a los hongos
-
Escribe su libro "Alexis Faramaca" donde menciona que los hongos son originarios de la tierra y se pueden encontrar en el suelo, que se originan por la acción de la lluvia. Este es la primera referencia de la micología.
-
Se tienen registros de que se cultivó por primera vez un hongo macroscópico comestible (Auricularia auricula-judae) en China
-
Se conocen datos de enfermedades por hongos o de la aplicación terapéutica de estos últimos por el Códice de Martín de la Cruz (manuscrito azteca).
-
Publicó su obra Theatrum fungorum, el primer texto dedicado a los hongos, cuya finalidad era ayudar a la identificación precisa de los hongos comestibles.
-
Fue el primero en observar levaduras
-
Elaboro el primer libro sobre micrografía de micromicetos donde indica que los hongos no tienen estructuras reproductivas. Relaciono los hongos macroscopicos con microscópicos.
-
En Europa se sabe que el champiñón (Agaricus campestris) se cultivó inicialmente en Francia.
-
A él se debe el término Aspergillus.
Funda la micologia con su libro "Nova Pantarum Genera".
Inoculo esporas en un medio por el preparado y obtuvo hongos. -
Agostino Bassi iniciador de la micología médica descubrió que la muscardina del gusano de seda era producida por un hongo (Beauveria bassiana).
-
Johann Lukas Schönlein estudió el hongo del favus
-
Bernhard Rudolph Conrad von Lagenbeck descubrió una levadura en el algodoncillo y en 1845 señaló la actinomicosis en humanos
-
David Gruby aisló el hongo del favus y reprodujo la enfermedad, también describió la tiña microscópica y cultivó Microsporum audouinii;
-
Charles Robin publicó el libro Histoire Naturelle des végétaux parasites, donde compiló los trabajos sobre dermatofitosis y su tratamiento tópico, así como la depilación en la tiña de la cabeza;
-
Describió y acuñó el término “micetoma”;
-
Se inoculó favus y pitiriasis versicolor
-
Identificó la tinea cruris debida a Epidermophyton floccosum, mientras que William Tilbury Fox identificó por su parte la tinea mannum.
-
Louis Charles Malassez identificó el “champignon de la pelade”
-
Estudió los primeros micetomas de América en Hermosillo, Sonora, México.
-
Clasificó los agentes causales de las dermatofitosis en cuatro grupos: Achorion, Epidermophyton, Trichophyton y Microsporum.
-
Definió la esporotricosis y su microorganismo causal.
-
Describió la histoplasmosis;
-
Lambert's American Spawn Company puso a la venta 7 diferentes cepas de Agaricus bisporus para venta a los productores Estadounidenses
-
Publicó el primer manual de micología dermatológica, considerado hoy como un clásico de la medicina y un modelo de la observación científica.
-
Bruno Bloch realizó los primeros estudios sobre inmunología de las micosis y efectuó estudios inyectando extractos de polisacáridos no purificados obtenidos a partir de colonias de dermatofitos
-
Cultivó el hongo, demostró su naturaleza dimorfa y reprodujo la enfermedad de modo experimental.
-
Antonio González Ochoa y E. Soto Figueroa, en México, aislaron un polisacárido de Sporothrix y contribuyeron mucho al diagnóstico y el estudio inmunológico de esta micosis
-
1947 Fernando Latapí, inició el tratamiento del actinomicetoma con sulfonas
-
Elaboraron los primeros extractos proteínicos con técnicas modernas y obtuvieron polisacáridos hidrosolubles con capacidad antigénica
-
Encontró que los indígenas de Guatemala asociaban a Amanita muscaria con los truenos.
-
Identifican 12 especies de Microsporum mediante análisis de ADN mitocondrial.
A list shows items. A timeline shows sequence.
Use Timetoast to make dates, milestones, and turning points easier to understand in a clear visual format. Timetoast is a timeline maker for work, school, research, and stories.